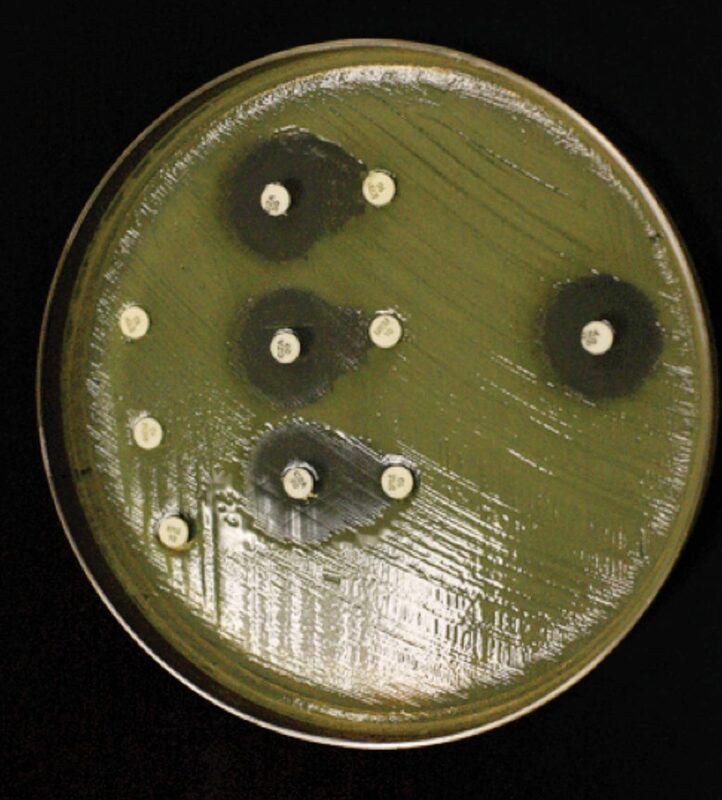
Гетерорезистентность - причина расхождения результатов тестов на чувствительность к антибиотикам

Тестирование на чувствительность к антибиотикам (AST) может быть важным этапом антибиотикотерапии и определяет необходимость использования препаратов, которые считаются эффективными in vitro против данного изолята.
Противоречивые результаты, получаемые при проведении тестов на чувствительность, могут привести к ошибкам при выборе антибиотиков для лечения и негативно сказаться на лечении пациентов. Причины расхождений в результатах AST в целом не ясны. Золотым стандартом AST считается метод микроразведений в бульоне (BMD); если результаты различных тестов противоречат результатам BMD, другие тесты считаются ошибочными. Широко сообщалось о расхождениях в результатах тестов на чувствительность к новым бета-лактамам цефидероколу, особенно в случаях карбапенем-резистентных Acinetobacter baumannii (CRAB). CRAB характеризуются высоким уровнем гетерорезистентности к цефидероколу - явлению, при котором изолят содержит незначительную субпопуляцию клеток, резистентных к данному антибиотику, что может быть выявлено с помощью теста анализа популяционного профиля (population analysis profile - PAP).
В настоящем исследовании мы изучили гетерорезистентность цефидерокола как потенциальную причину расхождения результатов AST в 211 клинических образцах. Статус чувствительности к цефидероколу изолятов CRAB (n=108) и карбапенем-резистентных Enterobacterales (n=103) сравнивали с помощью стандартных методов AST (BMD, диско-диффузия [DD], разведение в агаре) и PAP. Мы обнаружили, что расхождения в результатах AST могут быть вызваны наличием подгруппы гетерорезистентных изолятов с частотой резистентных клеток, которая слишком мала, чтобы быть выявленной как резистентная, но слишком высока, чтобы быть классифицированной как чувствительная.
PAP классифицировал 95 из 211 (45%) штаммов как гетерорезистентные и 116 (55%) из 211 штаммов как чувствительные к цефидероколу. Среди штаммов, отнесенных PAP к чувствительным, три стандартных теста совпадали при классификации 115 (99%) из 116 чувствительных штаммов; расхождения в результатах были отмечены только для одного изолята (1% из 116). Напротив, частота расхождения результатов стандартных тестов для штаммов, классифицированных как гетерорезистентные на основании PAP (24 [25%] из 95 штаммов), была выше, чем частота расхождений для штаммов, классифицированных как чувствительные по PAP.
Все стандартные тесты совпали в классификации девяти (9,5%) из 95 гетерорезистентных изолятов как нечувствительных, а среднее число резистентных клеток в этих штаммах составило одну на 1230 клеток. Стандартные тесты также совпали в классификации 62 (65%) из 95 гетерорезистентных изолятов как чувствительных, а средняя частота резистентных клеток в этих изолятах составила одну на 42 267 клеток. Напротив, результаты стандартных тестов расходились для 24 (25,3 %) из 95 гетерорезистентных изолятов, при этом средняя частота резистентных клеток составляла одну на 7178 клеток. В совокупности эти данные свидетельствуют о том, что почти все расхождения со стандартным AST обусловлены подгруппой гетерорезистентных изолятов с промежуточной частотой резистентных клеток.
Примечательно, что CLSI отметил недостаточную воспроизводимость результатов определения BMD цефидерокола, особенно для изолятов CRAB с минимальной ингибирующей концентрацией (МИК) выше 2 мкг/мл (брекпойнт по CLSI составляет 16 мкг/мл) и для изолятов с колониями в зоне очищения в DD, что усложняет интерпретацию результатов. Все изоляты CRAB с МИК 2 мкг/мл или выше и изоляты с колониями в зоне очищения в DD были классифицированы как гетерорезистентные к цефидероколу по PAP.
В совокупности эти данные указывают на то, что гетерорезистентность может объяснять расхождение в результатах AST, и предполагают, что более высокие МИК в диапазоне чувствительности, колонии в зоне очищения или оба фактора не должны игнорироваться и могут быть использованы в качестве маркеров гетерорезистентности. Результаты показывают, что этот биологический феномен приводит, по крайней мере, к некоторым расхождениям в результатах тестирования, и вносят большую ясность в понимание AST, что может помочь в составлении будущих рекомендаций и выборе значений брекпойнтов.